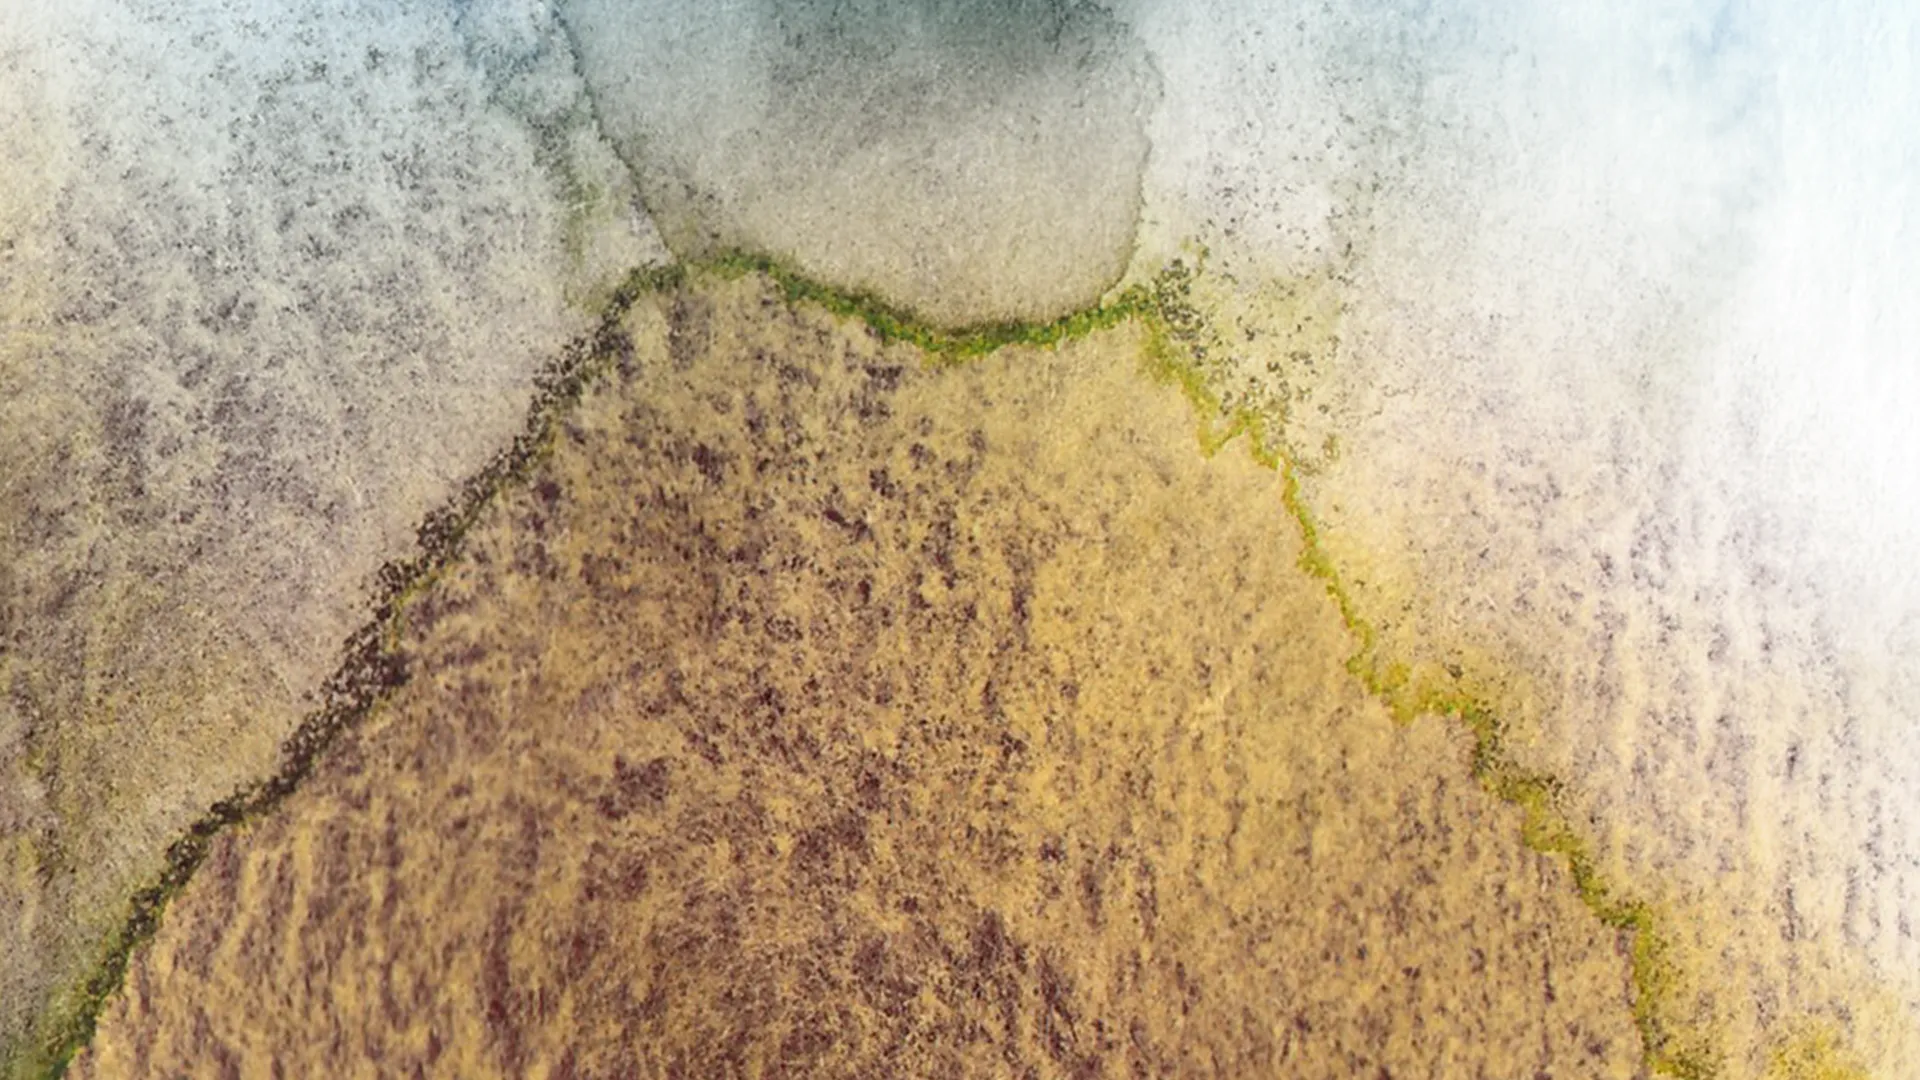

Breadcrumb
Rate guides set out recommended minimum rates and fees for independent contractors for various types of art and arts work. They have been created by organisations in the industry to support artists, arts workers and arts organisations to have conversations about pay and conditions. They provide benchmarks for what might be considered fair and reasonable.
The rates are a guide only and are not enforceable. Not all art forms have rate guides.
There are also minimum rates for employees.
Dance
The Dancers Australia Code of Practice 2025–26 sets out recommended minimum rates for dancers, dance teachers and choreographers across Australia.
Podcasting
Both the MEAA Podcast Rates Card and the Podcast Workers Australia Rate Card recommend minimums for a range of roles in the podcasting industry.
Screen
The Australian Directors' Guild Scripted Series Rate Card 2025–26 (PDF) sets out recommended minimum rates for scripted television directors, including updated conditions.
The 2024 Australian Screen Editors Rates & Conditions (PDF) includes recommended minimums for film including animation, television including commercials, documentaries and corporate work. Note: This guide includes information about super. From 1 July 2022 the $450 superannuation guarantee eligibility threshold no longer applies.
Visual arts
The NAVA Payment Standards includes recommended minimums for visual artists, craftspeople, designers and independent arts workers.
Writers, illustrators and literary award judges
The Australian Society of Authors Guidelines has recommended rates of pay for book illustrations, comics, freelance writing, poetry, literary award judging, and public and school appearances.
The Australian Writers Guild has industry standard rates for casual writing, theatre, television, film, documentary and corporate work. Access to these rates is for Guild members.
Have we missed any? Contact us if there are more we can add to this list.
More in this section:
About independent contractors: artists and arts workers
An independent contractor is someone who works for themselves. They are also sometimes called freelancers, self-managed artists, independent artists, sole traders or contractors.
Working out fees, payment and pricing
Self-employed artists and arts workers get to decide what price they will accept for their work. There are a few things to consider when working out the right price.
NSW and Qld performers and agents
In Queensland and NSW there are rules about how agents and managers pay and protect performers